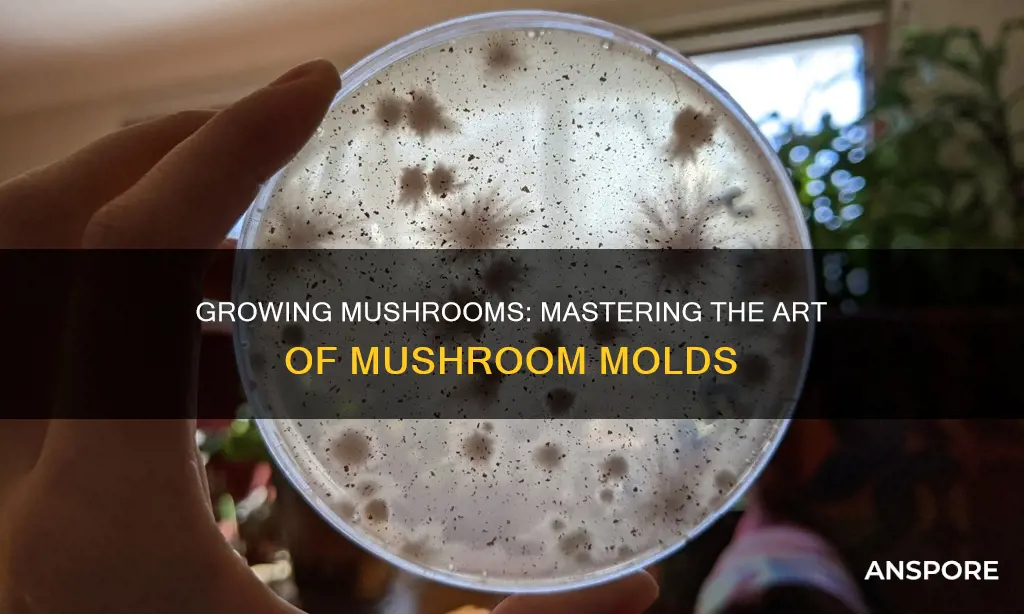
how do you do mushroom molds

Creating mushroom moulds is a fun and easy DIY project that can add a whimsical touch to your home decor. In this process, you'll be making concrete mushrooms that can be used outdoors or as part of a tablescape. The first step is to prepare the concrete mixture, which typically involves combining cement, water, sand, and rock. You can also use quick-setting concrete mix for faster results. Once you have your concrete mixture, you'll need to create moulds for the mushroom tops and stems using plastic containers or bowls. After filling the moulds with concrete, you can add details to the underside of the mushroom tops using a plastic fork to create the appearance of ribs. Let the concrete dry, and then remove it from the moulds. With a box cutter, carefully extract the mushroom stems by cutting a slit in the plastic containers. Assemble the mushroom tops and stems, and you've successfully created your own mushroom moulds!
| Characteristics | Values |
|---|---|
| What is a mold? | Molds are microbes that can be found in the divisions Zygomycota and Ascomycota. They cause biodegradation of natural materials and play important roles in biotechnology and food science. |
| How to identify mold? | Molds are microscopic fungi that develop a powdery, colored appearance, typically green, and have a distinct terrible smell. |
| Where does mold grow? | Molds can grow on dead organic matter and in artificial environments like buildings, where humidity and temperature foster their growth. |
| Health risks of mold | Molds can cause allergic reactions, respiratory problems, and other diseases in humans and animals due to allergic sensitivity, pathogenic mold growth, or ingestion of toxic compounds produced by molds. |
| Preventing mold on mushrooms | Store mushrooms below 40 degrees and avoid keeping them at room temperature in a sealed container. Cook mushrooms before eating to neutralize bacteria. |
| Artistic use of mold | Artists like Daniele Del Nero and Stacy Levy have used mold in their work to create unsettling natural scenes and macro-micro portraits. |
| Concrete mushroom molds | To create concrete mushroom molds, use a plastic container or can and mix concrete with water. Center a cardboard roll on the underside of the mold, insert it into the concrete, and press down. Draw lines on the underside of the mushroom top with a plastic fork to resemble ribs. Let the concrete dry and remove it from the mold. |
Explore related products
What You'll Learn

Concrete mushroom molds
Concrete mushroom moulds can be a fun DIY project to beautify your garden or table. You can use concrete mushroom moulds to create a forest-themed tablescape or add a whimsical touch to your garden. Here is a step-by-step guide to making concrete mushrooms:
Materials:
- Quick-setting concrete mix (a 25-lb box is usually sufficient)
- Water
- Plastic containers or cans for moulds (one for the mushroom cap and one for the stem)
- Cardboard paper towel or toilet paper roll
- Tape
- Plastic fork
- Box cutter
- Concrete glue (optional)
Instructions:
Step 1: Prepare the Concrete Mix
In a mixing container, combine the concrete powder with water, using approximately one part water to four parts concrete. Mix well until you achieve a pourable consistency. You may need to adjust by adding more water or concrete powder.
Step 2: Create the Mushroom Cap Mould
Take one of your plastic containers, preferably a bowl, and centre the cardboard roll (sealed-side down) in the middle. Insert the roll into the concrete and push it down about 1.5 to 2 inches. On the underside of the mushroom cap, use a plastic fork to create lines resembling the ribs of a mushroom.
Step 3: Create the Mushroom Stem Mould
Pour the concrete into the second mould, which will form the stem of the mushroom. Centre the same cardboard roll (sealed-side down) and insert it into the concrete as before.
Step 4: Let the Concrete Dry
Allow the concrete to dry completely. Quick-setting concrete usually dries within two hours.
Step 5: Remove the Moulds
Remove the mushroom cap and stem from their moulds. The plastic moulds can be carefully cut with a box cutter and peeled away from the concrete.
Step 6: Assemble the Mushroom
Place the mushroom cap on top of the stem. You can secure them together with concrete glue, but they should also rest comfortably without glue.
Step 7: Finishing Touches
Break off any rough pieces of concrete to smooth the surfaces. Use a plastic fork to add additional texture, if desired.
With these steps, you can create charming concrete mushrooms to enhance your indoor or outdoor spaces. Enjoy your DIY concrete mushroom adventure!
The Height of Nuclear Mushroom Clouds
You may want to see also

Distinguishing mushroom mycelium from mold
Distinguishing mushroom mycelium from mould is crucial when cultivating mushrooms. Mycelium is a white or off-white network of fibres that indicates healthy mushroom growth. It is the lifeblood of your mushroom kit. The appearance of mycelium can vary between species; for example, lion's mane mycelium may be finer, while oyster mushrooms can develop a thick, leathery mat.
Mould, on the other hand, usually has a distinctly different colour and a fuzzier texture than mycelium. Black, green, orange, or pink spots or patches on your mushroom kit are warning signs of potential mould contamination. Trichoderma, a genus of green mould, is one of the easiest types of contamination to identify, especially after sporulation, and one of the most difficult to contain. It is distinguished by its vibrant blue-green colour during sporulation. Cobweb mould, another common type of mould, is usually greyer and more wispy than typical mycelium, with very fine strands compared to the rope-like hyphal growth of mycelium, and a mildew smell.
To prevent mould, it is important to differentiate between mould and the mycelium that is essential for mushroom growth. Maintaining a sterile environment is key to preventing mould. Always work with clean hands and tools, and avoid introducing contaminants to your mushroom kit. Regular cleaning and disinfecting of surfaces are essential. To ensure a sterile environment, use a diluted bleach solution or isopropyl alcohol to wipe down surfaces, and sterilise tools with heat or a chemical agent before use.
Mushroom Slices: What's the Right Texture?
You may want to see also

Health risks of mold
Mould is a microscopic fungus that thrives in damp environments and can cause a range of health issues. While mould is different from the mushrooms we eat, it can lead to mould allergies and respiratory problems. This is a particular concern for those with pre-existing respiratory ailments, as even slight exposure to mould can worsen symptoms. In some cases, mould exposure can trigger allergic reactions, including sneezing, coughing, itchy eyes, and asthma attacks.
Mouldy mushrooms should always be discarded as they can pose serious health risks. When mould is present, its "root" threads have invaded the food deeply, and dangerous moulds often contain poisonous substances in and around these threads. These toxins may also have spread throughout the food. Consuming mouldy mushrooms can result in gastrointestinal distress and, in serious cases, mycotoxicosis, a toxic response to mycotoxin consumption.
Mycotoxins are toxic compounds produced by certain moulds, which can lead to a weakened immune system and neurotoxic effects. The mould species Aspergillus, for example, releases mycotoxins that are harmful if ingested or inhaled. Mycotoxins are primarily found in grain and nut crops but have also been detected in produce such as celery, grape juice, and apples. Aflatoxin, a cancer-causing poison produced by certain fungi, is one of the most well-known mycotoxins.
To avoid the health risks associated with mouldy mushrooms, it is important to store mushrooms correctly, typically below 40 degrees, and to inspect them thoroughly for any signs of mould before consumption. If there is any doubt about the edibility of a mushroom, it is best to discard it. Cooking mushrooms before eating can also help neutralise bacteria, especially in mushrooms that are not at peak freshness.
Shiitake Mushrooms: Identifying and Understanding Their Benefits
You may want to see also
Explore related products
$10.49 $13.99

Preventing mold on mushrooms
Mushrooms are a type of fungus, but they are distinct from mould, which is also a fungus. Moulds are usually microscopic and develop a powdery, coloured appearance, like green bread mould. Mould can cause allergic reactions and respiratory problems. Given enough time, mushrooms will also develop mould, especially if stored in a moist environment. Therefore, it is important to store mushrooms properly to prevent mould growth.
To prevent mould on mushrooms, it is recommended to keep them below 40 degrees to maintain freshness. If storing at room temperature, avoid using a sealed container as this can encourage botulism and other dangerous anaerobic bacteria. Instead, opt for breathable packaging like sugarcane clamshells or hole-punched plastic. Even with proper storage, mushrooms will eventually develop mould, usually a few weeks after harvest.
When checking for mould, it is important to examine the mushrooms closely. Some mushrooms, like chestnuts and oysters, may have white fuzz, which is likely mushroom mycelium rather than mould. This mycelium is harmless and does not affect the taste of the mushroom. However, if there is visible mould on the mushroom, it is best to discard the entire mushroom as scraping or cutting off the infected parts may not remove all the mould spores.
Additionally, cooking mushrooms can help neutralise bacteria, especially in mushrooms that are not at peak freshness. Sauteing or roasting are recommended cooking methods. By taking these preventive measures, you can reduce the likelihood of mould growth on mushrooms and ensure their safety for consumption.
Lasagna's Mushroom Mystery: To Add or Not?
You may want to see also

Art made from mold
Creating art from mould is a unique and intriguing concept. It involves using mould as a medium to create artwork that challenges our perceptions and blurs the lines between the beautiful and the repulsive, the living and the dead. Here are some examples of artists who have created captivating pieces using mould as their muse:
Elinart, also known as Elin Thomas, is a textile artist who crochets and sews mould patterns into fabric. Her pieces, sold on Etsy, include jewellery, modified handbags and wallets, and stand-alone or wall-hung artworks. Elinart's work captures the intricate details and textures of fungus and bacteria, presenting a unique and beautiful perspective on something often considered vile.
Daniele Del Nero constructs miniature haunted houses or city blocks in ruin using black paper, flour, and mould. His pieces evoke a sense of decay and prompt viewers to reflect on the environments they inhabit and the memories held within those spaces.
Gemma Schiebe employs a range of unconventional mediums, including sugar, cotton, and wool, to create mixed media sculptures, videos, and photographs that explore the process of decay. Her work juxtaposes perfectly formed fruit with fake mouldy exteriors, inviting viewers to question their perceptions of beauty and decay.
Another artist, C.L. Frost, focuses on photographing everyday objects and creating digital collages. One of their photographs, an untitled piece featuring mould on cream cheese, was featured on FridgeFungus.com, a website dedicated to celebrating the artful and unique nature of food gone bad.
Creating art from mould extends beyond traditional art forms. For example, some people create concrete mushroom sculptures using moulds for outdoor decor or tablescape designs. These mushrooms are crafted from a mixture of concrete, water, sand, and rock, and the process involves using plastic containers or cans as moulds.
Additionally, websites like Microbial Art showcase the work of microbiologists and biology labs that create bacteria drawings, living pictures, "bioglyphs," and "Bacteriograms." These artworks are often created using harmless moulds to form captivating visuals.
The art of mould challenges our perceptions and invites us to explore the intricate beauty that can arise from decay. It is a unique medium that blurs the boundaries between attraction and repulsion, offering a fresh perspective on the world around us.
Mushrooms: Brain Damage and You
You may want to see also

























